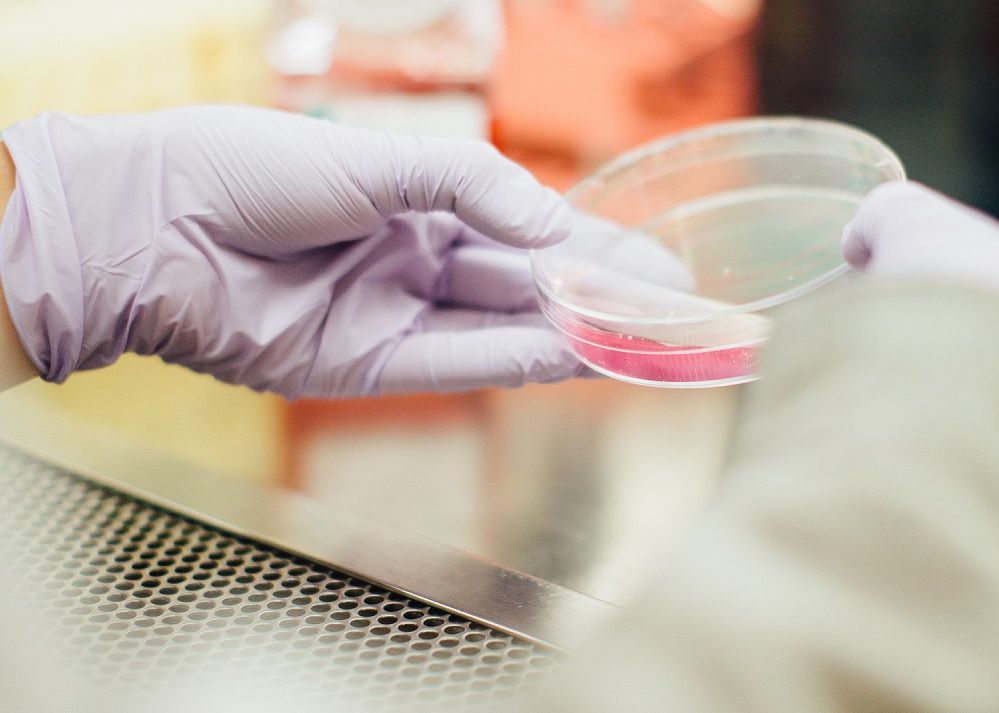
Premiul Nobel Pentru Medicina Acordat Cercetatorilor Care Au Descifrat Unul Dintre Marile Mistere Ale 1

Premiul Nobel pentru Medicina, acordat cercetatorilor care au descifrat unul dintre marile mistere ale lumii
Jeffrey C. Hall, Michael Rosbash si Michael W. Young au castigat premiul Nobel pentru Medicina pe 2017.
Cercetatorii Jeffrey C. Hall, Michael Rosbash si Michael W. Young au castigat premiul Nobel pentru Medicina pe 2017. Ei au fost premiati pentru ”descoperirile privind mecanismele moleculare in controlul ritmului circadian”, potrivit Comitetului Nobel, reunit, luni, la sediul Institutului Karolinska din Stockholm.
Cercetatorii americani Jeffrey C. Hall, Michael Rosbash si Michael W. Young au reusit sa vada in interiorul ceasului nostru biologic si sa elucideze cum functioneaza.
Descoperirile lor explica cum plantele, animalele si oamenii si-au adaptat ritmul biologic asa incat sa se sincronizeze cu revolutiile Pamantului, potrivit descrierii Academiei Suedeze.
Folosind muste de fructe, laureatii Nobel de anul acesta au extras o gena care controleaza ritmul normal biologic zilnic.
Ei au aratat ca aceasta gena codifica o proteina care se acumuleaza in celule in timpul noptii si este distrusa in timpul zilei. Apoi, ei au identificat proteine suplimentare care compun aceasta masinarie.
Se poate recunoaste acum functia ceasului biologic dupa aceleasi principii ca la celulele altor organisme multicelulare, inclusiv la oameni.
Jeffrey C. Hall s-a nascut in 1945 la New York, Statele Unite. El a primit diploma de doctor in 1971 la Universitatea Washington din Seattle si a urmat studii postdoctorale de cercetare la California Institute of Technology in Pasadena din 1971 pana in 1973. S-a alaturat Facultatii de la Brandeis University in Waltham din 1974. in 2002, a devenit asociat la Universitatea din Maine.
Michael Rosbash s-a nascut in 1944 in Kansas City, Statele Unite. El a primit diploma de doctor in 1970, la Massachusetts Institute of Technology la Cambridge. in anii urmatori el a urmat studii de cercetare postdoctorale la University of Edinburgh din Scoţia. Din 1974, a predat la facultate la Brandeis University din Waltham, Statele Unite.
Michael W. Young s-a nascut in 1949 la Miami, Statele Unite. El a primit diploma de doctor la University of Texas din Austin in 1975. intre 1975 si 1977, a fost cercetator postdoctoral la Stanford University in Palo Alto. Din 1978, a predat la Facultatea de la Universitatea Rockefeller din New York.
In 2016, cercetatorul japonez Yoshinori Ohsumi a castigat premiul Nobel pentru medicina, pentru ”descoperirea mecanismelor autofage”.
Din 1901 pana in 2016, au fost acordate 107 premii Nobel pentru Fiziologie sau Medicina.
Fiecare laureat Nobel primeste o diploma, o medalie din aur si un cec in valoare de 9 milioane de coroane suedeze (aproximativ 940.000 de euro).
Ceremoniile oficiale de inmanare a premiilor Nobel vor avea loc la Stockholm si Oslo pe 10 decembrie, ziua in care se comemoreaza moartea fondatorului acestor distincţii, industriasul si filantropul suedez Alfred Nobel (21 octombrie 1833 - 10 decembrie 1896).
Sursa: News.ro